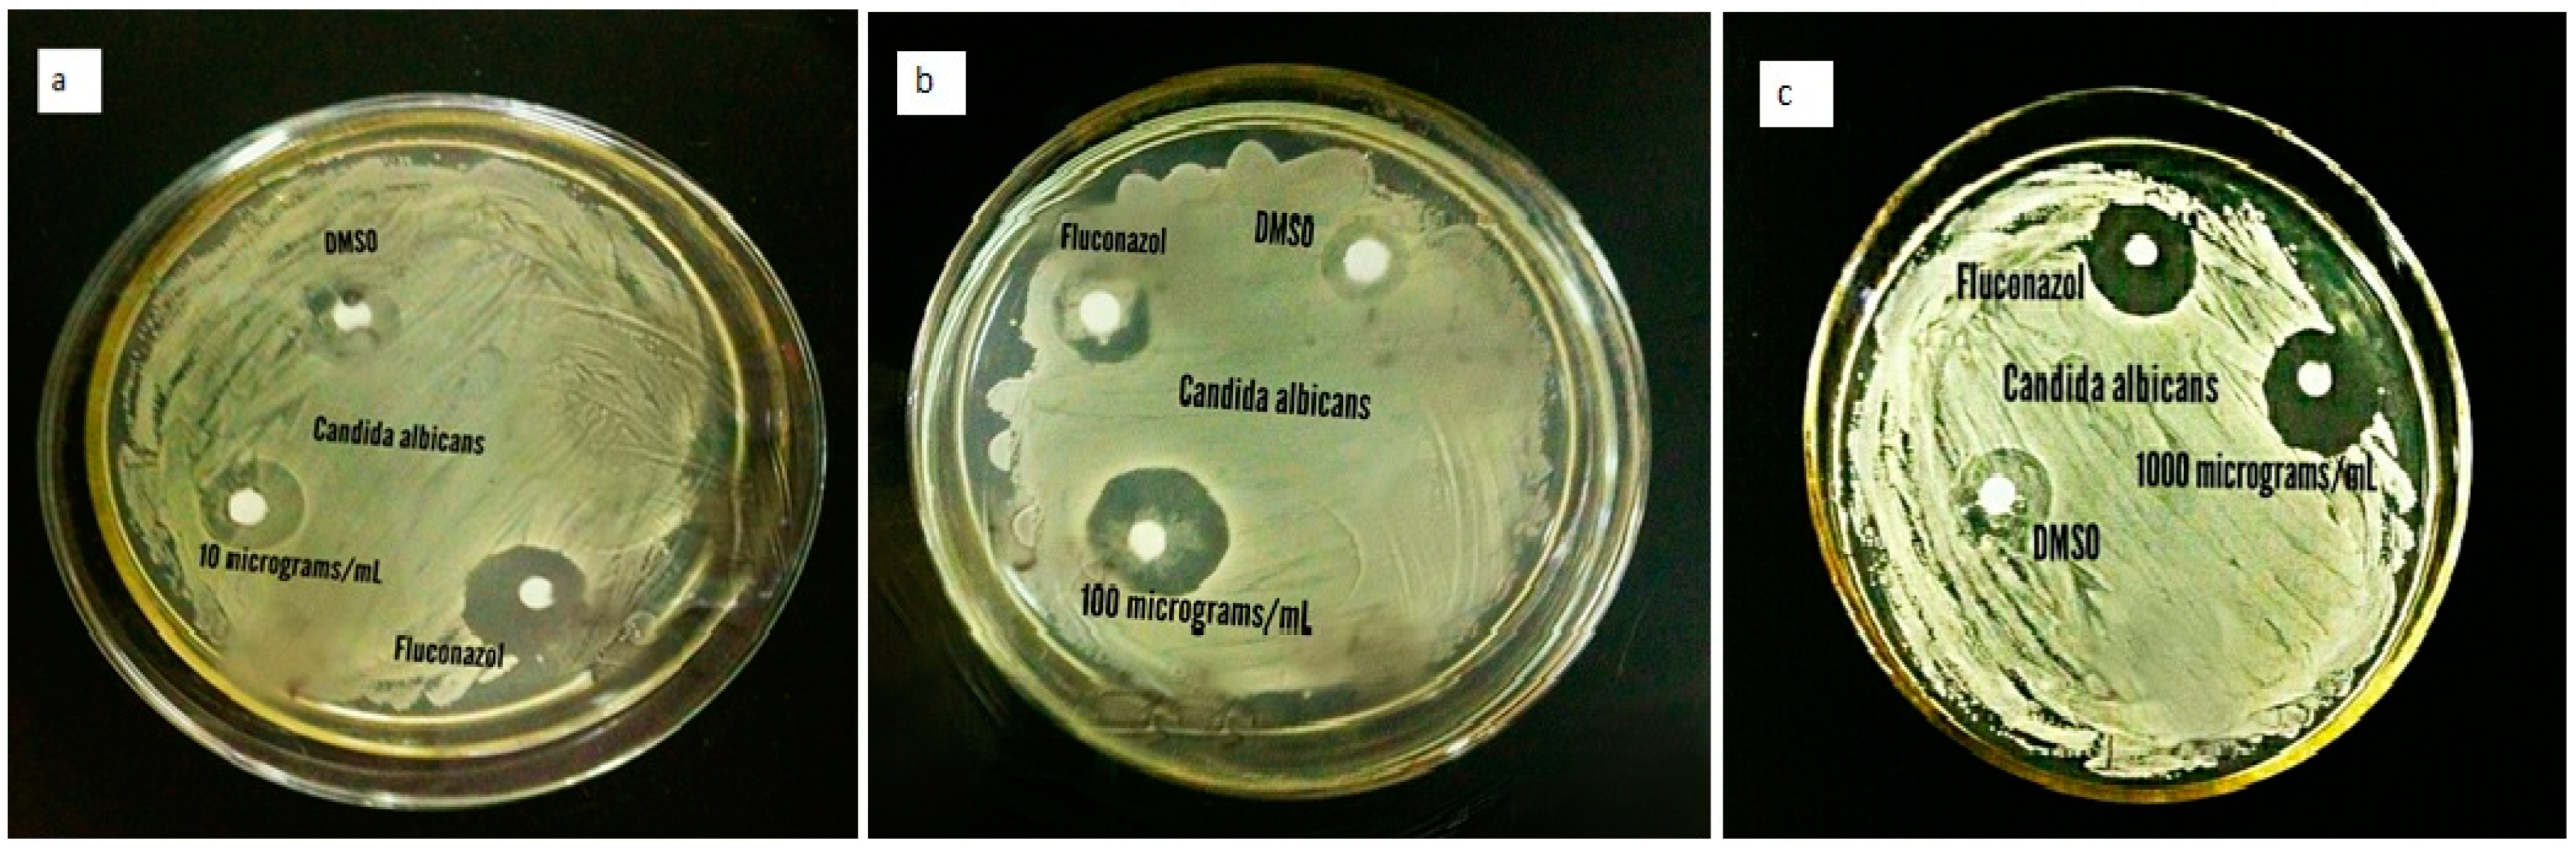

Green Synthesis, Characterization and Pharmaceutical Applications of Biocompatible Zinc Oxide Nanoparticles Using Heliotropium rariflorum Stocks
Abstract
1. Introduction
2. Results and Discussion
2.1. Characterization of ZnO-NPs
2.1.1. SEM
2.1.2. EDX Analysis

2.1.3. XRD Analysis
2.1.4. UV–Visible Spectrophotometry
2.1.5. FTIR
2.2. In Vitro Biological Properties
2.2.1. Antibacterial Activity
2.2.2. Antifungal Activity
2.2.3. Antioxidant Activity
2.3. Acute Toxicity Testing
2.4. In Vivo Biological Properties
2.4.1. Analgesic Activity
2.4.2. Antipyretic Activity
2.4.3. Sedative Activity
3. Materials and Methods
3.1. Plant Collection, Identification, and Grinding
3.2. Green Synthesis of Nanoparticles
3.3. Characterization of Synthesized Nanoparticles
3.3.1. Surface Morphology Analysis (SEM)
3.3.2. Energy-Dispersive X-Ray Analysis (EDX)
3.3.3. XRD
3.3.4. UV-Vis Spectroscopy
3.3.5. FTIR Spectroscopy
3.4. In Vitro Biological Properties of Biosynthesized ZnO-NPs
3.4.1. Antibacterial Activity
3.4.2. Antifungal Activity
3.4.3. Antioxidant Activity
3.5. Acute Toxicity Testing
3.6. In Vivo Pharmacological Evaluation of ZnO-NPs
3.6.1. Analgesic Activity
3.6.2. Antipyretic Activity
3.6.3. Sedative Activity
3.7. Statistical Analysis
4. Conclusions and Recommendations
Author Contributions
Funding
Institutional Review Board Statement
Informed Consent Statement
Data Availability Statement
Acknowledgments
Conflicts of Interest
References
- Abidullah, S.; Rauf, A.; Khan, S.W.; Ayaz, A.; Liaquat, F.; Saqib, S. A comprehensive review on distribution, paharmacological uses and biological activities of Argyrolobium roseum (Cambess.) Jaub. & Spach. Acta Ecol. Sin. 2022, 42, 198–205. [Google Scholar]
- Saqib, S.; Ullah, F.; Naeem, M.; Younas, M.; Ayaz, A.; Ali, S.; Zaman, W. Mentha: Nutritional and health attributes to treat various ailments including cardiovascular diseases. Molecules 2022, 27, 6728. [Google Scholar] [CrossRef] [PubMed]
- Hasan, M.; Altaf, M.; Zafar, A.; Hassan, S.G.; Ali, Z.; Mustafa, G.; Shu, X. Bioinspired synthesis of zinc oxide nano-flowers: A surface enhanced antibacterial and harvesting efficiency. Mater. Sci. Eng. C 2021, 119, 111280. [Google Scholar] [CrossRef] [PubMed]
- Soliman, M.K.; Salem, S.S.; Abu-Elghait, M.; Azab, M.S. Biosynthesis of silver and gold nanoparticles and their efficacy towards antibacterial, antibiofilm, cytotoxicity, and antioxidant activities. Appl. Biochem. Biotechnol. 2023, 195, 1158–1183. [Google Scholar] [CrossRef] [PubMed]
- Bandeira, M.; Possan, A.L.; Pavin, S.S.; Raota, C.S.; Vebber, M.C.; Giovanela, M.; Crespo, J.S. Mechanism of formation, characterization and cytotoxicity of green synthesized zinc oxide nanoparticles obtained from Ilex paraguariensis leaves extract. Nano-Struct. Nano-Objects 2020, 24, 100532. [Google Scholar] [CrossRef]
- Rajeswari, V.D.; Khalifa, A.S.; Elfasakhany, A.; Badruddin, I.A.; Kamangar, S.; Brindhadevi, K. Green and ecofriendly synthesis of cobalt oxide nanoparticles using Phoenix dactylifera L: Antimicrobial and photocatalytic activity. Appl. Nanosci. 2023, 13, 1367–1375. [Google Scholar] [CrossRef]
- Yaseen, B.; Gangwar, C.; Kumar, I.; Sarkar, J.; Naik, R.M. Detailed kinetic and mechanistic study for the preparation of silver nanoparticles by a chemical reduction method in the presence of a neuroleptic agent (Gabapentin) at an alkaline pH and its characterization. ACS Omega 2022, 7, 5739–5750. [Google Scholar] [CrossRef]
- Abdelghany, T.M.; Al-Rajhi, A.M.; Yahya, R.; Bakri, M.M.; Al Abboud, M.A.; Yahya, R.; Salem, S.S. Phytofabrication of zinc oxide nanoparticles with advanced characterization and its antioxidant, anticancer, and antimicrobial activity against pathogenic microorganisms. Biomass Convers. Biorefinery 2023, 13, 417–430. [Google Scholar] [CrossRef]
- Hussain, R.; Zafar, A.; Hasan, M.; Tariq, T.; Saif, M.S.; Waqas, M.; Shu, X. Casting zinc oxide nanoparticles using Fagonia blend microbial arrest. Appl. Biochem. Biotechnol. 2023, 195, 264–282. [Google Scholar] [CrossRef]
- Bouzekri, O.; El Gamouz, S.; Ed-Dra, A.; Moussout, H.; Dehmani, Y.; Ziyat, H.; Abouarnadasse, S. Green synthesis of nickel and copper nanoparticles doped with silver from Hammada scoparia leaf extract and evaluation of their potential to inhibit microorganisms and to remove dyes from aqueous solutions. Sustainability 2023, 15, 1541. [Google Scholar] [CrossRef]
- Acharjee, M.; Zerin, N.; Ishma, T.; Mahmud, M.R. In-vitro anti-bacterial activity of medicinal plants against urinary tract infection (UTI) causing bacteria along with their synergistic effects with commercially available antibiotics. New Microbes New Infect. 2023, 51, 101076. [Google Scholar] [CrossRef] [PubMed]
- Seo, C.; An, H.W.; Han, W.; Lee, J.W.; Shrestha, K.K.; Jung, W.K.; Lee, S.G. Screening of antioxidant capacity of Nepali medicinal plants with a novel singlet oxygen scavenging assay. Food Sci. Biotechnol. 2023, 32, 221–228. [Google Scholar] [CrossRef]
- Liu, H.; Kang, P.; Liu, Y.; An, Y.; Hu, Y.; Jin, X.; Wang, X. Zinc oxide nanoparticles synthesised from the Vernonia amygdalina shows the anti-inflammatory and antinociceptive activities in the mice model. Artif. Cells Nanomed. Biotechnol. 2020, 48, 1068–1078. [Google Scholar] [CrossRef] [PubMed]
- Tegegne, B.A.; Alehegn, A.A. Antipyretic potential of 80% methanol extract and solvent fractions of Bersama abyssinica Fresen. (melianthaceae) leaves against yeast-induced pyrexia in mice. J. Exp. Pharmacol. 2023, 15, 81–91. [Google Scholar] [CrossRef]
- Al-Radadi, N.S. Ephedra mediated green synthesis of gold nanoparticles (AuNPs) and evaluation of its antioxidant, antipyretic, anti-asthmatic, and antimicrobial properties. Arab. J. Chem. 2023, 16, 104353. [Google Scholar] [CrossRef]
- Tang, D.; Liang, Q.; Zhang, M.; Li, M.; Zhang, Q.; Zhang, S.; Wu, C. Anti-depression effectiveness of essential oil from the fruits of Zanthoxylum bungeanum maxim. on chronic unpredictable mild stress-induced depression behavior in mice. Front. Pharmacol. 2022, 13, 962–999. [Google Scholar] [CrossRef]
- Li, R.; Chen, X.; Ye, H.; Sheng, X. Green synthesis of gold nanoparticles from the extract of Crocus sativus to study the effect of antidepressant in adolescence and to observe its aggressive and impulsive behavior in rat models. S. Afr. J. Bot. 2024, 165, 455–465. [Google Scholar] [CrossRef]
- Nasir, E.; Ali, S.I. Flora of Pakistan; PARC: Islamabad, Pakistan, 1971–1995. [Google Scholar]
- Pandey, D.P.; Singh, J.P.; Roy, R.; Singh, V.P.; Pandey, V.B. Constituents of Heliotropium indicum. Orient. J. Chem. 1996, 12, 321–322. [Google Scholar]
- Paulraj, J.; Govindarajan, R.; Palpu, P. The genus Spilanthes ethnopharmacology, phytochemistry, and pharmacological properties: A review. Adv. Pharmacol. Sci. 2013, 22, 510298. [Google Scholar]
- Mohanraj, S.; Kulanthaivel, P.; Subramaniam, P.; Herz, W. Helifoline, a pyrrolizidine alkaloid from Heliotropium ovalifolium. Phytochem. 1981, 20, 1991–1995. [Google Scholar] [CrossRef]
- Kalyan, S.B.; Jasmin Sajni, R.; Karthik, R.; Raamamurthy, J.; Christina, A.; Sasikumar, S. Antiinflammatory and anti-nociceptive activities of Heliotropium indicum Linn. in experimental animal models. Phamacologyonline 2007, 3, 438–445. [Google Scholar]
- Rahman, S.; Parvin, M.N.; Chowdhury, S.A. Evaluation of anthelmintic, analgesic and neuropharmacological activity of Heliotropium indicum. Res. Rev. A J. Biotechnol. 2019, 9, 31–38. [Google Scholar]
- Khan, H.; Khan, M.A.; Hussain, S.; Gaffar, R.; Ashraf, N. In vivo antinociceptive and anticonvulsant activity of extracts of Heliotropium strigosum. Toxicol. Ind. Health 2016, 32, 860–865. [Google Scholar] [CrossRef]
- Hussain, S.; Jamil, M.; Ullah, F.; Khan, A.; Ullah, F.; Arfan, M.; Khatoon, L. Antimicrobial and antioxidant activities of the plant Heliotropium strigosum. Afr. J. Biotechnol. 2010, 9, 7738–7743. [Google Scholar]
- Ahmad, S.; Bibi, I.; AbdEl-Salam, N.M.; Hussain, H.; Ishaq, M.S.; Adnan, M.; Ullah, R. Antibacterial and antifungal activities of the extract and fractions of aerial parts of Heliotropium bacciferum. Afr. J. Tradit. Complement. Altern. Med. 2015, 12, 32–35. [Google Scholar] [CrossRef][Green Version]
- Singh, B.; Sahu, P.M.; Sharma, R.A. Flavonoids from Heliotropium subulatum exudate and their evaluation for antioxidant, antineoplastic and cytotoxic activities II. Cytotechnology 2017, 69, 103–115. [Google Scholar] [CrossRef]
- Elumalai, K.; Velmurugan, S.; Ravi, S.; Kathiravan, V.; Adaikala Raj, G. Bio-approach: Plant mediated synthesis of ZnO nanoparticles and their catalytic reduction of methylene blue and antimicrobial activity. Adv. Powder Technol. 2015, 6, 1639–1651. [Google Scholar] [CrossRef]
- Fagier, M.A. Plant-mediated biosynthesis and photocatalysis activities of zinc oxide nanoparticles: A prospect towards dyes mineralization. J. Nanotechnol. 2021, 2021, 6629180. [Google Scholar] [CrossRef]
- Nazir, A.; Raza, M.; Abbas, M.; Abbas, S.; Ali, A.; Ali, Z.; Iqbal, M. Microwave assisted green synthesis of ZnO nanoparticles using Rumex dentatus leaf extract: Photocatalytic and antibacterial potential evaluation. Z. Für Phys. Chem. 2022, 236, 1203–1217. [Google Scholar] [CrossRef]
- Tarroum, M.; Alfarraj, N.S.; Al-Qurainy, F.; Al-Hashimi, A.; Khan, S.; Nadeem, M.; Shaikhaldein, H.O. Improving the production of secondary metabolites via the application of biogenic zinc oxide nanoparticles in the calli of Delonix elata: A potential medicinal plant. Metabolites 2023, 13, 905. [Google Scholar] [CrossRef]
- Maher, S.; Zamina, B.; Riaz, M.; Riaz, S.; Khalid, N.; Imran, M.; Parveen, S. Green synthesis of Withania coagulans extract-mediated zinc oxide nanoparticles as photocatalysts and biological agents. ACS Omega 2023, 8, 46715–46727. [Google Scholar] [CrossRef] [PubMed]
- Awan, S.S.; Khan, R.T.; Mehmood, A.; Hafeez, M.; Abass, S.R.; Nazir, M.; Raffi, M. Ailanthus altissima leaf extract mediated green production of zinc oxide (ZnO) nanoparticles for antibacterial and antioxidant activity. Saudi J. Biol. Sci. 2023, 30, 103487. [Google Scholar]
- Ihsan, M.; Din, I.U.; Alam, K.; Munir, I.; Mohamed, H.I.; Khan, F. Green fabrication, characterization of zinc oxide nanoparticles using plant extract of Momordica charantia and Curcuma zedoaria and their antibacterial and antioxidant activities. Appl. Biochem. Biotechnol. 2023, 195, 3546–3565. [Google Scholar] [CrossRef]
- Murali, M.; Gowtham, H.G.; Shilpa, N.; Singh, S.B.; Aiyaz, M.; Sayyed, R.Z.; Kollur, S.P. Zinc oxide nanoparticles prepared through microbial mediated synthesis for therapeutic applications: A possible alternative for plants. Front. Microbiol. 2023, 14, 1227951. [Google Scholar] [CrossRef]
- Miri, A.; Sarani, M. Biosynthesis and cytotoxic study of synthesized zinc oxide nanoparticles using Salvadora persica. BioNanoScience 2019, 9, 164–171. [Google Scholar] [CrossRef]
- Rashid, M.U.; Shah, S.J.; Attacha, S.; Khan, L.; Saeed, J.; Shah, S.T.; Mohamed, H.I. Green synthesis and characterization of zinc oxide nanoparticles using Citrus limetta peels extract and their antibacterial activity against brown and soft rot pathogens and antioxidant potential. Waste Biomass Valorization 2024, 3, 3351–3366. [Google Scholar] [CrossRef]
- Samy, A.; El-Sherbiny, A.E.; Menazea, A.A. Green synthesis of high impact zinc oxide nanoparticles. Egypt. J. Chem. 2019, 62, 29–37. [Google Scholar] [CrossRef]
- Menazea, A.A.; Ismail, A.M.; Samy, A. Novel green synthesis of zinc oxide nanoparticles using orange waste and its thermal and antibacterial activity. J. Inorg. Organomet. Polym. Mater. 2021, 31, 4250–4259. [Google Scholar] [CrossRef]
- Bala, N.; Saha, S.; Chakraborty, M.; Maiti, M.; Das, S.; Basu, R.; Nandy, P. Green synthesis of zinc oxide nanoparticles using Hibiscus subdariffa leaf extract: Effect of temperature on synthesis, anti-bacterial activity and anti-diabetic activity. RSC Adv. 2015, 5, 4993–5003. [Google Scholar] [CrossRef]
- Leuner, C.; Dressman, J. Improving drug solubility for oral delivery using solid dispersions. Eur. J. Pharm. Biopharm. 2000, 50, 47–60. [Google Scholar] [CrossRef]
- Wang, J.X.; Zhang, Q.X.; Zhou, Y.; Shao, L.; Chen, J.F. Microfluidic synthesis of amorphous cefuroxime axetil nanoparticles with size-dependent and enhanced dissolution rate. Chem. Eng. J. 2010, 162, 844–851. [Google Scholar] [CrossRef]
- Jog, R.; Burgess, D.J. Pharmaceutical amorphous nanoparticles. J. Pharm. Sci. 2017, 106, 39–65. [Google Scholar] [CrossRef] [PubMed]
- Tan, S.T.; Chen, B.J.; Sun, X.W.; Fan, W.J.; Kwok, H.S.; Zhang, X.H.; Chua, S.J. Blueshift of optical band gap in ZnO thin films grown by metal-organic chemical-vapor deposition. J. Appl. Phys. 2005, 98, 013505. [Google Scholar] [CrossRef]
- Debanath, M.K.; Karmakar, S.J.M.L. Study of blueshift of optical band gap in zinc oxide (ZnO) nanoparticles prepared by low-temperature wet chemical method. Mater. Lett. 2013, 111, 116–119. [Google Scholar] [CrossRef]
- Jayachandran, A.; Aswathy, T.R.; Nair, A.S. Green synthesis and characterization of zinc oxide nanoparticles using Cayratia pedata leaf extract. Biochem. Biophys. Rep. 2021, 26, 100995. [Google Scholar] [CrossRef] [PubMed]
- Hamed, R.; Obeid, R.Z.; Abu-Huwaij, R. Plant mediated-green synthesis of zinc oxide nanoparticles: An insight into biomedical applications. Nanotechnol. Rev. 2023, 12, 20230112. [Google Scholar] [CrossRef]
- Murali, M.; Kalegowda, N.; Gowtham, H.G.; Ansari, M.A.; Alomary, M.N.; Alghamdi, S. Plant-mediated zinc oxide nanoparticles: Advances in the new millennium towards understanding their therapeutic role in biomedical applications. Pharmaceutics 2021, 3, 1662. [Google Scholar] [CrossRef]
- MuthuKathija, M.; Badhusha, M.S.M.; Rama, V. Green synthesis of zinc oxide nanoparticles using Pisonia alba leaf extract and its antibacterial activity. Appl. Surf. Sci. Adv. 2023, 15, 100400. [Google Scholar] [CrossRef]
- Mohammed, Y.H.I.; Alghamdi, S.; Jabbar, B.; Marghani, D.; Beigh, S.; Abouzied, A.S.; Hozzein, W.N. Green synthesis of zinc oxide nanoparticles using Cymbopogon citratus extract and its antibacterial activity. ACS Omega 2023, 8, 32027–32042. [Google Scholar] [CrossRef]
- Rajeshkumar, S.; Roy, A.; Santhoshkumar, J.; Lakshmi, T. Herbal formulation mediated synthesis of silver nanoparticles and its antifungal activity against Candida albicans. Indian J. Public Health Res. Dev. 2019, 10, 3454–3458. [Google Scholar]
- Rasheed, T.; Nabeel, F.; Bilal, M.; Iqbal, H.M. Biogenic synthesis and characterization of cobalt oxide nanoparticles for catalytic reduction of direct yellow-142 and methyl orange dyes. Biocatal. Agric. Biotechnol. 2019, 19, 101154. [Google Scholar] [CrossRef]
- Khalafi, T.; Buazar, F.; Ghanemi, K. Phycosynthesis and enhanced photocatalytic activity of zinc oxide nanoparticles toward organosulfur pollutants. Sci. Rep. 2019, 9, 6866. [Google Scholar] [CrossRef] [PubMed]
- Sharmila, G.; Muthukumaran, C.; Sandiya, K.; Santhiya, S.; Pradeep, R.S.; Kumar, N.M.; Thirumarimurugan, M. Biosynthesis, characterization, and antibacterial activity of zinc oxide nanoparticles derived from Bauhinia tomentosa leaf extract. J. Nanostruct. Chem. 2018, 8, 293–299. [Google Scholar] [CrossRef]
- Kavitha, A.; Doss, A.; Pole, R.P.; Rani, T.K.P.; Prasad, R.; Satheesh, S. A mini review on plant-mediated zinc oxide nanoparticles and their antibacterial potency. Biocatal. Agric. Biotechnol. 2023, 48, 102654. [Google Scholar] [CrossRef]
- Yang, X.; Cao, X.; Chen, C.; Liao, L.; Yuan, S.; Huang, S. Green synthesis of zinc oxide nanoparticles using aqueous extracts of Hibiscus cannabinus L.: Wastewater purification and antibacterial activity. Separations 2023, 10, 466. [Google Scholar] [CrossRef]
- Dastidar, M.G.; Nallal, V.U.M.; Thulasiram, E.; Muthupandi, S.; Razia, M.; Rajendran, S.; Ravindran, B. Phyto-mediated synthesis of zinc oxide nanoparticles using Clematis montana extract and evaluation of its antibacterial activity. Appl. Nanosci. 2023, 13, 5959–5966. [Google Scholar] [CrossRef]
- Mwafy, A.; Youssef, D.Y.; Mohamed, M.M. Antibacterial activity of zinc oxide nanoparticles against some multidrug-resistant strains of Escherichia coli and Staphylococcus Aureus. Z. Für Phys. Chem. 2023, 23, 120–129. [Google Scholar]
- Fouda, A.; Saied, E.; Eid, A.M.; Kouadri, F.; Alemam, A.M.; Hamza, M.F.; Hassan, S.E.D. Green synthesis of zinc oxide nanoparticles using an aqueous extract of Punica granatum for antimicrobial and catalytic activity. J. Funct. Biomater. 2023, 14, 205. [Google Scholar] [CrossRef]
- Xie, J.; Li, H.; Zhang, T.; Song, B.; Wang, X.; Gu, Z. Recent advances in ZnO nanomaterial-mediated biological applications and action mechanisms. Nanomaterials 2023, 13, 1500. [Google Scholar] [CrossRef]
- Arthur, M.; Aliero, A.A.; Odda, J. Antibacterial activity of ethanol crude extracts of whole plant of the Ugandan Phyllanthus amarus Schumach. & Thonn against Shigella dysenteriae. BMC Complement. Med. Ther. 2019, 2, 33–36. [Google Scholar]
- Velsankar, K.; Parvathy, G.; Mohandoss, S.; Krishna, K.M.; Sudhahar, S. Celosia argentea leaf extract-mediated green synthesized iron oxide nanoparticles for bio-applications. J. Nanostruct. Chem. 2021, 12, 625–640. [Google Scholar] [CrossRef]
- Das, S.K.; Khan, M.M.R.; Guha, A.K.; Naskar, N. Bio-inspired fabrication of silver nanoparticles on nanostructured silica: Characterization and application as a highly efficient hydrogenation catalyst. Green Chem. 2013, 15, 2548–2557. [Google Scholar] [CrossRef]
- Ogu, G.I.; Ezeadila, J.; Ehiobu, J.M. Antioxidant and antimicrobial activities of Dialium guineense (Willd) leaf extract. Pharm. Pharmacol. Res. 2013, 1, 1–7. [Google Scholar]
- Sharma, A.; Nagraik, R.; Venkidasamy, B.; Khan, A.; Dulta, K.; Kumar, C.P.; Shin, D.S. In vitro antidiabetic, antioxidant, antimicrobial, and cytotoxic activity of Murraya koenigii leaf extract intercedes ZnO nanoparticles. Luminescence 2023, 38, 1139–1148. [Google Scholar] [CrossRef]
- Kamal, A.; Saba, M.; Ullah, K.; Almutairi, S.M.; AlMunqedhi, B.M.; Ragab abdelGawwad, M. Mycosynthesis, characterization of zinc oxide nanoparticles, and its assessment in various biological activities. Crystals 2023, 13, 171. [Google Scholar] [CrossRef]
- Kamel, S.M.; Elgobashy, S.F.; Omara, R.I.; Derbalah, A.S.; Abdelfatah, M.; El-Shaer, A.; Elsharkawy, M.M. Antifungal activity of copper oxide nanoparticles against root rot disease in cucumber. J. Fungi 2022, 8, 911. [Google Scholar] [CrossRef]
- Ghavam, M.; Afzali, A.; Manca, M.L. Chemotype of damask rose with oleic acid (9 octadecenoic acid) and its antimicrobial effectiveness. Sci. Rep. 2021, 11, 8027. [Google Scholar] [CrossRef] [PubMed]
- Kalaimurgan, D.; Lalitha, K.; Govindarajan, R.K.; Unban, K.; Shivakumar, M.S.; Venkatesan, S.; Adil, M. Biogenic synthesis of zinc oxide nanoparticles using Drynaria ouercifolia tuber extract for antioxidant, antibiofilm, larvicidal, and photocatalytic applications. Biomass Convers. Biorefinery 2023, 1–17. [Google Scholar] [CrossRef]
- Chemingui, H.; Moulahi, A.; Missaoui, T.; Al-Marri, A.H.; Hafiane, A. A novel green preparation of zinc oxide nanoparticles with Hibiscus sabdariffa L.: Photocatalytic performance, evaluation of antioxidant and antibacterial activity. Environ. Technol. 2024, 45, 926–944. [Google Scholar] [CrossRef]
- Ahani, H.; Attaran, S. Therapeutic potential of Seabuckthorn (Hippophae rhamnoides L.) in medical sciences. Cell. Mol. Biomed. Rep. 2022, 2, 22–32. [Google Scholar] [CrossRef]
- Fazeli-Nasab, B.; Ghafari, M.; Jahantigh, M.; Beigomi, Z.; Saeidi, S. Evaluation of phenolic and flavonoid content, alkaloids, antioxidant capacity and antibacterial properties of methanolic extract of Zahak native medicinal plants against seven pathogens. J. Med. Plants By-Prod. 2023, 13, 57–65. [Google Scholar]
- Jafri, S.A.A.; Khalid, Z.M.; Khan, M.R.; Ashraf, S.; Ahmad, N.; Karami, A.M.; Aslam, S. Evaluation of some essential traditional medicinal plants for their potential free scavenging and antioxidant properties. J. King Saud Univ. Sci. 2023, 35, 102562. [Google Scholar] [CrossRef]
- Shaban, E.; Salaheldin, K.; El-Aziz, A.; Essam, M.; M Desouky, H.; F Elbakry, H. Evaluation of acute oral toxicity of zinc oxide nanoparticles in rats. Egypt. J. Chem. 2021, 64, 4591–4600. [Google Scholar] [CrossRef]
- Pasupuleti, S.; Alapati, S.; Ganapathy, S.; Anumolu, G.; Pully, N.R.; Prakhya, B.M. Toxicity of zinc oxide nanoparticles through oral route. Toxicol. Ind. Health 2012, 28, 675–686. [Google Scholar] [CrossRef]
- Sharma, V.; Singh, P.; Pandey, A.K.; Dhawan, A. Induction of oxidative stress, DNA damage and apoptosis in mouse liver after sub-acute oral exposure to zinc oxide nanoparticles. Mutat. Res. 2012, 745, 84–91. [Google Scholar] [CrossRef]
- Ho, M.; Wu, K.Y.; Chein, H.M.; Chen, L.C.; Cheng, T.J. Pulmonary toxicity of inhaled nanoscale and fine zinc oxide particles: Mass and surface area as an exposure metric. Inhal. Toxicol. 2011, 23, 947–956. [Google Scholar] [CrossRef]
- Xu, Y.; Wang, W.; Ma, L.; Cui, X.; Lynch, I.; Wu, G. Acute toxicity of Zinc Oxide nanoparticles to silkworm (Bombyx mori L.). Chemosphere 2020, 259, 127481. [Google Scholar] [CrossRef]
- Djouadi, A.; Derouiche, S. Spinach mediated synthesis of zinc oxide nanoparticles: Characterization, in vitro biological activities study and in vivo acute toxicity evaluation. Curr. Res. Green Sustain. Chem. 2021, 4, 100214. [Google Scholar] [CrossRef]
- Devientasaria, C.; Putri, L.A.M. Effect test of analgesics (paracetamol, ibuprofen, and antalgin) in local strain male mice with acetic acid induction using the writhing test method. Str. J. Pharm. 2023, 5, 11–15. [Google Scholar]
- Liu, H.; Zheng, S.; Xiong, H.; Alwahibi, M.S.; Niu, X. Biosynthesis of copper oxide nanoparticles using Abies spectabilis plant extract and analyzing its anti-nociceptive and anti-inflammatory potency in various mice models. Arab. J. Chem. 2020, 13, 6995–7006. [Google Scholar] [CrossRef]
- Rauf, A.; Al-Awthan, Y.S.; Khan, I.A.; Muhammad, N.; Ali, S.S.U.; Bahattab, O.; Rahman, M.M. In vivo anti-inflammatory, analgesic, muscle relaxant, and sedative activities of extracts from Syzygium cumini (L.) skeels in mice. Evid. Based Complement. Altern. Med. 2022, 2022, 6307529. [Google Scholar] [CrossRef] [PubMed]
- Amin, Z.S.; Afzal, M.; Ahmad, J.; Ahmed, N.; Zeshan, B.; Hashim, N.H.H.N.; Yean, C.Y. Synthesis, characterization and biological activities of zinc oxide nanoparticles derived from secondary metabolites of Lentinula edodes. Molecules 2023, 28, 3532. [Google Scholar] [CrossRef] [PubMed]
- Hajjaj, G.; Bahlouli, A.; Sayah, K.; Tajani, M.; Cherrah, Y.; Zellou, A. Phytochemical screening and in-vivo antipyretic activity of the aqueous extracts of three Moroccan medicinal plants. Pharm. Biol. Eval. 2017, 4, 188–192. [Google Scholar] [CrossRef]
- Nawaz, I.; Tahir, A.; Iqbal, S.M.; Anjum, F.; Naseem, M.; Aslam, M.I.; Jamil, Q. Anti-inflammatory, anti-nociceptive and anti-pyretic activities of Cenchrus ciliaris L. J. Ethnopharmacol. 2023, 309, 116332. [Google Scholar] [CrossRef] [PubMed]
- Ain, Q.U.; Iqbal, M.O.; Khan, I.A.; Bano, N.; Naeem, M.; Jamaludin, M.I.; Devaraj, S. Phytochemical, antioxidant, antipyretic and anti-inflammatory activities of aqueous-methanolic leaf extract of Mangifera indica. Am. J. Transl. Res. 2023, 15, 4533. [Google Scholar]
- Ajaykumar, A.P.; Mathew, A.; Chandni, A.P.; Varma, S.R.; Jayaraj, K.N.; Sabira, O.; Chatterjee, S. Green synthesis of silver nanoparticles using the leaf extract of the medicinal plant, Uvaria narum and its antibacterial, antiangiogenic, anticancer and catalytic properties. Antibiotics 2023, 12, 564. [Google Scholar] [CrossRef]
- Wang, Z.; Que, B.; Gan, J.; Guo, H.; Chen, Q.; Zheng, L.; Zhang, Y. Zinc oxide nanoparticles synthesized from Fraxinus rhynchophylla extract by green route method attenuates the chemical and heat induced neurogenic and inflammatory pain models in mice. J. Photochem. Photobiol. B Biol. 2020, 202, 111668. [Google Scholar] [CrossRef] [PubMed]
- Mutukwa, D.; Taziwa, R.T.; Khotseng, L. A review of plant-mediated ZnO nanoparticles for photodegradation and antibacterial applications. Nanomaterials 2024, 14, 1182. [Google Scholar] [CrossRef]
- Bass, A.K.; Abdelhafez, E.; El-Zoghbi, M.; Mohamed, M.F.; Badr, M.; Abuo-Rahma, G.E.D.A. 3-Cyano-2-oxa-pyridines: A promising template for diverse pharmacological activities. J. Adv. Biomed. Pharm. Sci. 2021, 4, 81–86. [Google Scholar] [CrossRef]
- Hassan, F.; Edo, G.I.; Nwosu, L.C.; Jalloh, A.A.; Onyibe, P.N.; Itoje-akpokiniovo, L.O.; Irogbo, P.U. An inventory of medicinal plants used as sedative, analgesic and blood tonic in Abeokuta, Ogun State, Nigeria. Acta Ecol. Sin. 2023, 43, 459–468. [Google Scholar] [CrossRef]
- Nasir, Y.J. Boraginaceae. Flora Pak. 1989, 191, 1–5. [Google Scholar]
- Pandiyan, R.; Ilango, K. Pharmacognostical, physicochemical and phytochemical evaluation of Huberantha senjiana (Annonaceae) leaf: An endemic tree of Gingee Hills Tamil Nadu India. J. Pharm. Pharmacogn. Res. 2022, 10, 158–172. [Google Scholar] [CrossRef]
- Basit, R.A.; Abbasi, Z.; Hafeez, M.; Ahmad, P.; Khan, J.; Khandaker, M.U.; Khalid, A. Successive photocatalytic degradation of methylene blue by ZnO, CuO and ZnO/CuO synthesized from Coriandrum sativum plant extract via green synthesis technique. Crystals 2023, 13, 281. [Google Scholar] [CrossRef]
- Dua, T.K.; Giri, S.; Nandi, G.; Sahu, R.; Shaw, T.K.; Paul, P. Green synthesis of silver nanoparticles using Eupatorium adenophorum leaf extract: Characterizations, antioxidant, antibacterial and photocatalytic activities. Chem. Pap. 2023, 77, 2947–2956. [Google Scholar] [CrossRef]
- Takele, E.; Feyisa, B.R.; Shumi, G.; Kenasa, G. Green synthesis, characterization, and antibacterial activity of CuO/ZnO nanocomposite using Zingiber officinale rhizome extract. J. Chem. 2023, 1, 3481389. [Google Scholar] [CrossRef]
- Ameen, F.; Al-Homaidan, A.A.; Al-Sabri, A.; Almansob, A.; AlNAdhari, S. Anti-oxidant, anti-fungal and cytotoxic effects of silver nanoparticles synthesized using marine fungus Cladosporium halotolerans. Appl. Nanosci. 2023, 13, 623–631. [Google Scholar] [CrossRef]
- Lorke, D. A new approach to practical acute toxicity testing. Arch. Toxicol. 1983, 54, 275–287. [Google Scholar] [CrossRef] [PubMed]
- Shen, T.; Wang, Q.; Liu, C.; Yu, F.; Yu, D.; Li, C. Euphorbia milii extract-mediated zinc oxide nanoparticles and their antinociceptive, muscle relaxant, and sedative activities for pain management in pediatric children. Appl. Nanosci. 2020, 10, 1297–1303. [Google Scholar] [CrossRef]
- Sulaiman, S.; Ahmad, S.; Naz, S.S.; Qaisar, S.; Muhammad, S.; Ullah, R.; Gulnaz, A. Synthesis of zinc oxide based etoricoxib and montelukast nanoformulations and their evaluation through analgesic, anti-inflammatory, anti-pyretic and acute toxicity activities. J. King Saud Univ. Sci. 2022, 34, 101938. [Google Scholar] [CrossRef]
- Islam, M.R.; Naima, J.; Proma, N.M.; Hussain, M.S.; Uddin, S.N.; Hossain, M.K. In-vivo and in-vitro evaluation of pharmacological activities of Ardisia solanacea leaf extract. Clin. Phytosci. 2019, 5, 32. [Google Scholar] [CrossRef]

| S. NO | Concentration (μg/mL) | Ascorbic Acid | Blank | ZnO-NPs |
|---|---|---|---|---|
| (%) Free Radical Scavenging | ||||
| 1 | 5 | 90.30 | 0 | 45 |
| 2 | 10 | 92.15 | 48.2 | |
| 3 | 20 | 95 | 50.21 | |
| 4 | 30 | 95.17 | 55.44 | |
| 5 | 40 | 95.22 | 59.13 | |
| 6 | 60 | 96 | 79.34 | |
| 7 | 80 | 97.40 | 80.30 | |
| 8 | 100 | 97.45 | 85.28 | |
| IC50 values | 0.0079 | 12.085 | ||
| Behavior Observations | ZnO-NPs (mg/kg) | Duration | |||||
|---|---|---|---|---|---|---|---|
| Mortality | Control | 0 h | 2 h | 4 h | 8 h | 24 h | 36 h |
| 5 | None | None | None | None | None | None | |
| 10 | None | None | None | None | None | None | |
| 20 | None | None | None | None | None | None | |
| Feed and water consumption | 5 | Normal | Normal | Normal | Normal | Normal | Normal |
| 10 | Normal | Normal | Normal | Normal | Normal | Normal | |
| 20 | Normal | Normal | Normal | Normal | Normal | Normal | |
| Diarrhea | 5 | None | None | None | None | None | None |
| 10 | None | None | None | None | None | None | |
| 20 | None | None | None | None | None | None | |
| Movement | 5 | Normal | Normal | Normal | Normal | Normal | Normal |
| 10 | Normal | Normal | Normal | Normal | Normal | Normal | |
| 20 | Normal | Normal | Normal | Normal | Normal | Normal | |
| Treatments | Dose (mg/kg) Body Weight | Writhing (Mean ± SEM) | % Inhibition | ||
|---|---|---|---|---|---|
| After 5 min | After 10 min | After 15 min | |||
| Normal saline (10 mL/kg) | 33.00 ± 0.76 | 33.00 ± 0.76 | 32.00 ± 0.93 | 0 | |
| Tramadol | 30 | 15.20 ± 0.67 | 14.00 ± 0.44 | 6.00 ± 0.44 | 81 |
| ZnO-NPs | 5 | 11.60 ± 1.02 | 10.00 ± 0.67 | 4.40 ± 0.92 | 86.25 *** |
| 10 | 8.80 ± 0.48 | 5.60 ± 0.24 | 4.00 ± 0.24 | 88 *** | |
| 20 | 8.00 ± 0.63 | 4.40 ± 0.24 | 3.00 ± 0.19 | 91 *** | |
| Treatment | Dose (mg/kg) Body Weight | Body Temperature (°C) (Mean ± SEM) | ||||
|---|---|---|---|---|---|---|
| Normal | After Yeast Injection (0 h) | After 1 h | After 2 h | After 3 h | ||
| Normal saline (10 mL/kg) | 37.00 ± 0.19 | 38.29 ± 0.08 | 38.17 ± 0.16 | 38.00 ± 0.04 | 38.00 ± 0.03 | |
| Paracetamol | 20 | 37.00 ± 0.05 | 38.04 ± 0.02 | 37.22 ± 0.01 | 37.00 ± 0.21 | 36.04 ± 0.01 |
| ZnO-NPs | 5 | 37.08 ±0.03 | 37.49 ± 0.22 | 37.00 ± 0.16 | 37.50 ± 0.16 | 37.24 ± 0.11 *** |
| 10 | 37.11 ± 0.03 | 37.48 ± 0.16 | 37.00 ± 0.10 | 36.22 ± 0.12 | 36.10 ± 0.223 *** | |
| 20 | 37.10 ± 0.04 | 37.30 ± 0.08 | 36.14 ± 0.044 | 36.11 ± 0.02 | 36.03 ± 0.01 *** | |
| Treatments | Dose (mg/kg) Body Weight | Number of Lines Crossed in 10 min (Mean ± SEM) | Movement Inhibition (%) |
|---|---|---|---|
| Normal saline (10 mL/kg) | 127.00 ± 0.67 | 0 | |
| Diazepam | 0.5 | 5.00 ± 0.31 | 96.0 |
| ZnO-NPs | 5 | 43.00 ± 1.93 | 66.0 |
| 10 | 38.20 ± 1.77 | 70.0 | |
| 20 | 23.20 ± 0.58 | 82.0 | |
Disclaimer/Publisher’s Note: The statements, opinions and data contained in all publications are solely those of the individual author(s) and contributor(s) and not of MDPI and/or the editor(s). MDPI and/or the editor(s) disclaim responsibility for any injury to people or property resulting from any ideas, methods, instructions or products referred to in the content. |
© 2024 by the authors. Licensee MDPI, Basel, Switzerland. This article is an open access article distributed under the terms and conditions of the Creative Commons Attribution (CC BY) license (https://creativecommons.org/licenses/by/4.0/).
Share and Cite
Uza, N.U.; Dastagir, G.; Shah, S.T.; Pavlova, E.; Jamal, A.; Seleiman, M.F.; Černý, J. Green Synthesis, Characterization and Pharmaceutical Applications of Biocompatible Zinc Oxide Nanoparticles Using Heliotropium rariflorum Stocks. Pharmaceuticals 2024, 17, 1457. https://doi.org/10.3390/ph17111457
Uza NU, Dastagir G, Shah ST, Pavlova E, Jamal A, Seleiman MF, Černý J. Green Synthesis, Characterization and Pharmaceutical Applications of Biocompatible Zinc Oxide Nanoparticles Using Heliotropium rariflorum Stocks. Pharmaceuticals. 2024; 17(11):1457. https://doi.org/10.3390/ph17111457
Chicago/Turabian StyleUza, Noor Ul, Ghulam Dastagir, Syed Tanveer Shah, Elitsa Pavlova, Aftab Jamal, Mahmoud F. Seleiman, and Jakub Černý. 2024. "Green Synthesis, Characterization and Pharmaceutical Applications of Biocompatible Zinc Oxide Nanoparticles Using Heliotropium rariflorum Stocks" Pharmaceuticals 17, no. 11: 1457. https://doi.org/10.3390/ph17111457
APA StyleUza, N. U., Dastagir, G., Shah, S. T., Pavlova, E., Jamal, A., Seleiman, M. F., & Černý, J. (2024). Green Synthesis, Characterization and Pharmaceutical Applications of Biocompatible Zinc Oxide Nanoparticles Using Heliotropium rariflorum Stocks. Pharmaceuticals, 17(11), 1457. https://doi.org/10.3390/ph17111457

